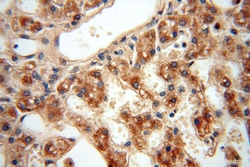

Antibody data
- Antibody Data
- Antigen structure
- References [23]
- Comments [0]
- Validations
- Western blot [1]
- Immunocytochemistry [1]
- Immunohistochemistry [2]
Submit
Validation data
Reference
Comment
Report error
- Product number
- 15999-1-AP - Provider product page

- Provider
- Proteintech Group
- Proper citation
- Proteintech Cat#15999-1-AP, RRID:AB_2258817
- Product name
- ATP5F1 antibody
- Antibody type
- Polyclonal
- Description
- ATP5F1 antibody (Cat. #15999-1-AP) is a rabbit polyclonal antibody that shows reactivity with human, mouse, rat and has been validated for the following applications: IF, IHC, WB,ELISA.
- Reactivity
- Human, Mouse, Rat
- Host
- Rabbit
- Conjugate
- Unconjugated
- Isotype
- IgG
- Vial size
- 20ul, 150ul
Submitted references Supramolecular Hydrogel with Ultra-Rapid Cell-Mediated Network Adaptation for Enhancing Cellular Metabolic Energetics and Tissue Regeneration.
A high-fat diet increases hepatic mitochondrial turnover through restricted acetylation in a NAFLD mouse model.
Acetylation of Atp5f1c Mediates Cardiomyocyte Senescence via Metabolic Dysfunction in Radiation-Induced Heart Damage.
Human TRUB1 is a highly conserved pseudouridine synthase responsible for the formation of Ψ55 in mitochondrial tRNAAsn, tRNAGln, tRNAGlu and tRNAPro.
Bromodomain-containing protein 4 (BRD4) as an epigenetic regulator of fatty acid metabolism genes and ferroptosis.
Mitochondrial and glucose metabolic dysfunctions in granulosa cells induce impaired oocytes of polycystic ovary syndrome through Sirtuin 3.
ROS/PI3K/Akt and Wnt/β-catenin signalings activate HIF-1α-induced metabolic reprogramming to impart 5-fluorouracil resistance in colorectal cancer.
GABA regulates IL-1β production in macrophages.
Mitochondrial remodeling and ischemic protection by G protein-coupled receptor 35 agonists.
An animal model for mitochondrial tyrosyl-tRNA synthetase deficiency reveals links between oxidative phosphorylation and retinal function.
Spermine Protects Cardiomyocytes from High Glucose-Induced Energy Disturbance by Targeting the CaSR-gp78-Ubiquitin Proteasome System.
Differential mitochondrial proteomic analysis of A549 cells infected with avian influenza virus subtypes H5 and H9.
Transcriptomics of single dose and repeated carbon black and ozone inhalation co-exposure highlight progressive pulmonary mitochondrial dysfunction.
COA6 Facilitates Cytochrome c Oxidase Biogenesis as Thiol-reductase for Copper Metallochaperones in Mitochondria.
Heat Stress Impairs the Physiological Responses and Regulates Genes Coding for Extracellular Exosomal Proteins in Rat.
A Mutation in Hnrnph1 That Decreases Methamphetamine-Induced Reinforcement, Reward, and Dopamine Release and Increases Synaptosomal hnRNP H and Mitochondrial Proteins.
Urea transport B gene induces melanoma B16 cell death via activation of p53 and mitochondrial apoptosis.
Calcium sensing receptor protects high glucose-induced energy metabolism disorder via blocking gp78-ubiquitin proteasome pathway.
F1FO ATP Synthase Is Expressed at the Surface of Embryonic Rat Heart-Derived H9c2 Cells and Is Affected by Cardiac-Like Differentiation.
Assembly of human mitochondrial ATP synthase through two separate intermediates, F1-c-ring and b-e-g complex.
Evaluation of intramitochondrial ATP levels identifies G0/G1 switch gene 2 as a positive regulator of oxidative phosphorylation.
Proteomic study reveals a co-occurrence of gallic acid-induced apoptosis and glycolysis in B16F10 melanoma cells.
Ech1 is a potent suppressor of lymphatic metastasis in hepatocarcinoma.
Li Z, Yang B, Yang Z, Xie X, Guo Z, Zhao J, Wang R, Fu H, Zhao P, Zhao X, Chen G, Li G, Wei F, Bian L
Advanced materials (Deerfield Beach, Fla.) 2024 Apr;36(15):e2307176
Advanced materials (Deerfield Beach, Fla.) 2024 Apr;36(15):e2307176
A high-fat diet increases hepatic mitochondrial turnover through restricted acetylation in a NAFLD mouse model.
Aghayev M, Arias-Alvarado A, Ilchenko S, Lepp J, Scott I, Chen YR, Zhang GF, Tsai TH, Kasumov T
American journal of physiology. Endocrinology and metabolism 2023 Jul 1;325(1):E83-E98
American journal of physiology. Endocrinology and metabolism 2023 Jul 1;325(1):E83-E98
Acetylation of Atp5f1c Mediates Cardiomyocyte Senescence via Metabolic Dysfunction in Radiation-Induced Heart Damage.
Zeng Z, Xu P, He Y, Yi Y, Liu Z, Cai J, Huang L, Liu A
Oxidative medicine and cellular longevity 2022;2022:4155565
Oxidative medicine and cellular longevity 2022;2022:4155565
Human TRUB1 is a highly conserved pseudouridine synthase responsible for the formation of Ψ55 in mitochondrial tRNAAsn, tRNAGln, tRNAGlu and tRNAPro.
Jia Z, Meng F, Chen H, Zhu G, Li X, He Y, Zhang L, He X, Zhan H, Chen M, Ji Y, Wang M, Guan MX
Nucleic acids research 2022 Sep 9;50(16):9368-9381
Nucleic acids research 2022 Sep 9;50(16):9368-9381
Bromodomain-containing protein 4 (BRD4) as an epigenetic regulator of fatty acid metabolism genes and ferroptosis.
Yang M, Liu K, Chen P, Zhu H, Wang J, Huang J
Cell death & disease 2022 Oct 29;13(10):912
Cell death & disease 2022 Oct 29;13(10):912
Mitochondrial and glucose metabolic dysfunctions in granulosa cells induce impaired oocytes of polycystic ovary syndrome through Sirtuin 3.
Zhang Q, Ren J, Wang F, Pan M, Cui L, Li M, Qu F
Free radical biology & medicine 2022 Jul;187:1-16
Free radical biology & medicine 2022 Jul;187:1-16
ROS/PI3K/Akt and Wnt/β-catenin signalings activate HIF-1α-induced metabolic reprogramming to impart 5-fluorouracil resistance in colorectal cancer.
Dong S, Liang S, Cheng Z, Zhang X, Luo L, Li L, Zhang W, Li S, Xu Q, Zhong M, Zhu J, Zhang G, Hu S
Journal of experimental & clinical cancer research : CR 2022 Jan 8;41(1):15
Journal of experimental & clinical cancer research : CR 2022 Jan 8;41(1):15
GABA regulates IL-1β production in macrophages.
Fu J, Han Z, Wu Z, Xia Y, Yang G, Yin Y, Ren W
Cell reports 2022 Dec 6;41(10):111770
Cell reports 2022 Dec 6;41(10):111770
Mitochondrial remodeling and ischemic protection by G protein-coupled receptor 35 agonists.
Wyant GA, Yu W, Doulamis IP, Nomoto RS, Saeed MY, Duignan T, McCully JD, Kaelin WG Jr
Science (New York, N.Y.) 2022 Aug 5;377(6606):621-629
Science (New York, N.Y.) 2022 Aug 5;377(6606):621-629
An animal model for mitochondrial tyrosyl-tRNA synthetase deficiency reveals links between oxidative phosphorylation and retinal function.
Jin X, Zhang Z, Nie Z, Wang C, Meng F, Yi Q, Chen M, Sun J, Zou J, Jiang P, Guan MX
The Journal of biological chemistry 2021 Jan-Jun;296:100437
The Journal of biological chemistry 2021 Jan-Jun;296:100437
Spermine Protects Cardiomyocytes from High Glucose-Induced Energy Disturbance by Targeting the CaSR-gp78-Ubiquitin Proteasome System.
Wang Y, Wang Y, Li F, Zhang X, Li H, Yang G, Xu C, Wei C
Cardiovascular drugs and therapy 2021 Feb;35(1):73-85
Cardiovascular drugs and therapy 2021 Feb;35(1):73-85
Differential mitochondrial proteomic analysis of A549 cells infected with avian influenza virus subtypes H5 and H9.
Yang Y, Zhang Y, Yang C, Fang F, Wang Y, Chang H, Chen Z, Chen P
Virology journal 2021 Feb 18;18(1):39
Virology journal 2021 Feb 18;18(1):39
Transcriptomics of single dose and repeated carbon black and ozone inhalation co-exposure highlight progressive pulmonary mitochondrial dysfunction.
Hathaway QA, Majumder N, Goldsmith WT, Kunovac A, Pinti MV, Harkema JR, Castranova V, Hollander JM, Hussain S
Particle and fibre toxicology 2021 Dec 15;18(1):44
Particle and fibre toxicology 2021 Dec 15;18(1):44
COA6 Facilitates Cytochrome c Oxidase Biogenesis as Thiol-reductase for Copper Metallochaperones in Mitochondria.
Pacheu-Grau D, Wasilewski M, Oeljeklaus S, Gibhardt CS, Aich A, Chudenkova M, Dennerlein S, Deckers M, Bogeski I, Warscheid B, Chacinska A, Rehling P
Journal of molecular biology 2020 Mar 27;432(7):2067-2079
Journal of molecular biology 2020 Mar 27;432(7):2067-2079
Heat Stress Impairs the Physiological Responses and Regulates Genes Coding for Extracellular Exosomal Proteins in Rat.
Dou J, Khan A, Khan MZ, Mi S, Wang Y, Yu Y, Wang Y
Genes 2020 Mar 13;11(3)
Genes 2020 Mar 13;11(3)
A Mutation in Hnrnph1 That Decreases Methamphetamine-Induced Reinforcement, Reward, and Dopamine Release and Increases Synaptosomal hnRNP H and Mitochondrial Proteins.
Ruan QT, Yazdani N, Blum BC, Beierle JA, Lin W, Coelho MA, Fultz EK, Healy AF, Shahin JR, Kandola AK, Luttik KP, Zheng K, Smith NJ, Cheung J, Mortazavi F, Apicco DJ, Ragu Varman D, Ramamoorthy S, Ash PEA, Rosene DL, Emili A, Wolozin B, Szumlinski KK, Bryant CD
The Journal of neuroscience : the official journal of the Society for Neuroscience 2020 Jan 2;40(1):107-130
The Journal of neuroscience : the official journal of the Society for Neuroscience 2020 Jan 2;40(1):107-130
Urea transport B gene induces melanoma B16 cell death via activation of p53 and mitochondrial apoptosis.
Liu L, Sun Y, Zhao Y, Wang Q, Guo H, Guo R, Liu Y, Fu S, Zhang L, Li Y, Meng Y
Cancer science 2018 Dec;109(12):3762-3773
Cancer science 2018 Dec;109(12):3762-3773
Calcium sensing receptor protects high glucose-induced energy metabolism disorder via blocking gp78-ubiquitin proteasome pathway.
Wang Y, Gao P, Wei C, Li H, Zhang L, Zhao Y, Wu B, Tian Y, Zhang W, Wu L, Wang R, Xu C
Cell death & disease 2017 May 18;8(5):e2799
Cell death & disease 2017 May 18;8(5):e2799
F1FO ATP Synthase Is Expressed at the Surface of Embryonic Rat Heart-Derived H9c2 Cells and Is Affected by Cardiac-Like Differentiation.
Comelli M, Domenis R, Buso A, Mavelli I
Journal of cellular biochemistry 2016 Feb;117(2):470-82
Journal of cellular biochemistry 2016 Feb;117(2):470-82
Assembly of human mitochondrial ATP synthase through two separate intermediates, F1-c-ring and b-e-g complex.
Fujikawa M, Sugawara K, Tanabe T, Yoshida M
FEBS letters 2015 Sep 14;589(19 Pt B):2707-12
FEBS letters 2015 Sep 14;589(19 Pt B):2707-12
Evaluation of intramitochondrial ATP levels identifies G0/G1 switch gene 2 as a positive regulator of oxidative phosphorylation.
Kioka H, Kato H, Fujikawa M, Tsukamoto O, Suzuki T, Imamura H, Nakano A, Higo S, Yamazaki S, Matsuzaki T, Takafuji K, Asanuma H, Asakura M, Minamino T, Shintani Y, Yoshida M, Noji H, Kitakaze M, Komuro I, Asano Y, Takashima S
Proceedings of the National Academy of Sciences of the United States of America 2014 Jan 7;111(1):273-8
Proceedings of the National Academy of Sciences of the United States of America 2014 Jan 7;111(1):273-8
Proteomic study reveals a co-occurrence of gallic acid-induced apoptosis and glycolysis in B16F10 melanoma cells.
Liu C, Lin JJ, Yang ZY, Tsai CC, Hsu JL, Wu YJ
Journal of agricultural and food chemistry 2014 Dec 3;62(48):11672-80
Journal of agricultural and food chemistry 2014 Dec 3;62(48):11672-80
Ech1 is a potent suppressor of lymphatic metastasis in hepatocarcinoma.
Zhang J, Sun M, Li R, Liu S, Mao J, Huang Y, Wang B, Hou L, Ibrahim MM, Tang J
Biomedicine & pharmacotherapy = Biomedecine & pharmacotherapie 2013 Sep;67(7):557-60
Biomedicine & pharmacotherapy = Biomedecine & pharmacotherapie 2013 Sep;67(7):557-60
No comments: Submit comment
Supportive validation
- Submitted by
- Proteintech Group (provider)
- Main image

- Experimental details
- mouse liver tissue were subjected to SDS PAGE followed by western blot with 15999-1-AP(ATP5F1 antibody) at dilution of 1:1000
- Sample type
- tissue
Supportive validation
- Submitted by
- Proteintech Group (provider)
- Main image

- Experimental details
- Immunofluorescent analysis of Hela cells, using ATP5F1 antibody 15999-1-AP at 1:25 dilution and Rhodamine-labeled goat anti-rabbit IgG (red).
- Sample type
- cell line
Supportive validation
- Submitted by
- Proteintech Group (provider)
- Main image

- Experimental details
- Immunohistochemical of paraffin-embedded human liver using 15999-1-AP(ATP5F1 antibody) at dilution of 1:100 (under 10x lens)
- Sample type
- tissue
- Submitted by
- Proteintech Group (provider)
- Main image
- Experimental details
- Immunohistochemical of paraffin-embedded human liver using 15999-1-AP(ATP5F1 antibody) at dilution of 1:100 (under 40x lens)
- Sample type
- tissue